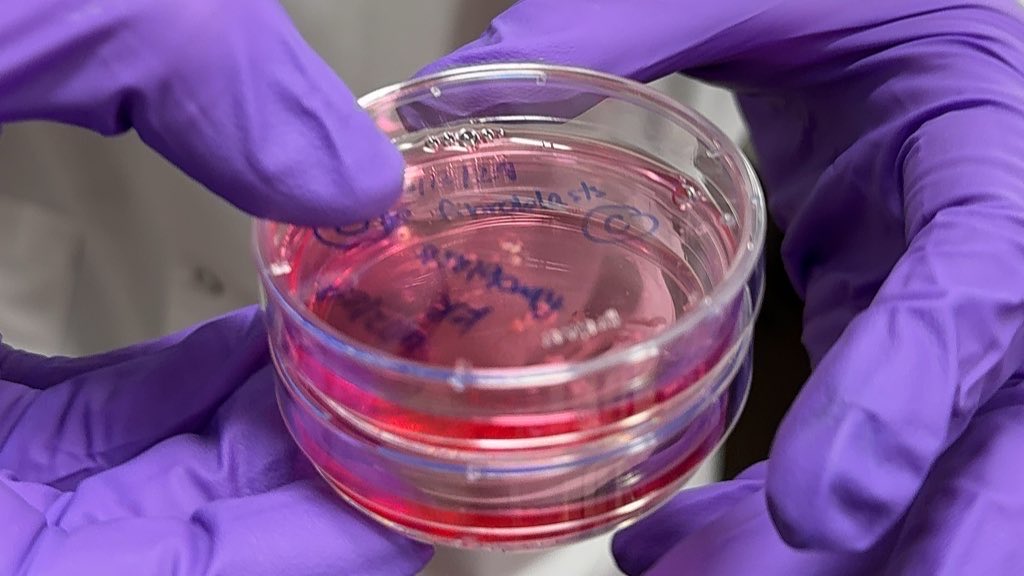
Lifespan tweet media

Dr. Sinclair recently spoke @StevenBartlett about his lab's research @harvardmed on age reversal. Meanwhile Steven wore an age-suit & learned what it's like for older people who haven't staved off aging
youtu.be/DnvWAP99r3Y
open.spotify.com/episode/7fEZDl…

YouTube


English